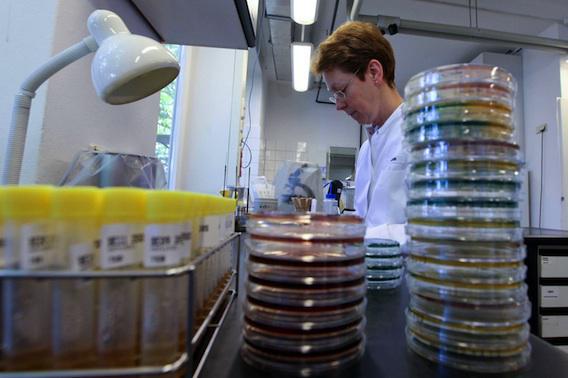

Equipe Inserm
Staphylocoque doré : des Français découvrent deux cibles thérapeutiques
Grâce à deux toxines, le staphylocoque doré est capable de détruire les globules rouges pour leur "voler" leur fer. Bloquer l'action de ces molécules est une piste thérapeutique.
- Par Anne-Laure Lebrun
- Commenting
- DROESE/SIPA
Pour survivre et infecter son hôte, le staphylocoque doré détruit les globules rouges, et y puise du fer, révèle une étude française publiée dans le journal Cell Host & Microbes. Une découverte qui ouvre la voie à de nouveaux traitements.
Cette bactérie, au premier rang des germes responsables des infections nosocomiales, est particulièrement redoutable quand les défenses immunitaires des patients s’affaiblissent. Les scientifiques savent que le staphylocoque doré est gourmand en fer, un nutriment essentiel à sa reproduction. Or, celui-ci n’est retrouvé qu’en très faible quantité à l’état libre dans le sang. Reste alors les globules rouges, dont l'hémoglobine contient beaucoup de fer. Mais par quels moyens les staphylocoques réussissent-ils à s’en emparer ?
Deux toxines responsables
Pour répondre à cette question, 3 équipes Inserm et une équipe américaine ont collaboré. Leurs travaux ont démarré quand deux toxines sécrétées par les staphylocoques dorés, LukED et HlgAB, ont été découvertes. Ces molécules se fixent à un récepteur présent à la surface des cellules immunitaires, pour les détruire. Or, un homologue de ce récepteur, DARC, existe à la surface des globules rouges. Les chercheurs ont donc exploré le rôle de ces toxines et de DARC dans l’infection par staphylocoque doré.
Pour ce faire, les scientifiques ont étudié les hématies de personnes originaires d’Afrique sub-saharienne car « environ 90 % de cette population possède des globules rouges déficients ou très pauvres en DARC ». Résultat : un déficit de ce récepteur est associé à une résistance des globules rouges aux toxines.
Des essais chez l'homme fin 2015
Ainsi, grâce à ces protéines et par l’intermédiaire du récepteur, la bactérie semble capable de détruire les cellules sanguines pour subvenir à ses besoins en fer. Pour le vérifier, les chercheurs ont testé 3 conditions de culture. Dans la première, les bactéries ont été placées dans un milieu sans fer et dans les deux autres, les bactéries ont été mises en présence de fer libre ou de globules rouge. Il apparaît alors qu’elles ne se multiplient pas dans le premier cas alors qu’elles prolifèrent dans les deux autres. Ceci confirme que le staphylocoque doré est en mesure de détruire les globules rouges humains, pour se nourrir de son fer.
La découverte de ces deux molécules offre donc un espoir de lutte contre cette bactérie multirésistante aux antibiotiques. « Deux toxines sont en effet beaucoup plus faciles à cibler qu’un récepteur chez l’hôte, note le chercheur. En outre, bloquer leur activité permettrait de faire d’une pierre deux coups, en les empêchant de détruire à la fois les neutrophiles (globules blancs, NDLR) et les globules rouges ».
Un laboratoire développe actuellement deux anticorps monoclonaux dirigés contre six toxines produites par le staphylocoque doré, dont LukED et HlgAB. Les premiers essais chez l’homme devraient démarrer dès la fin 2015.